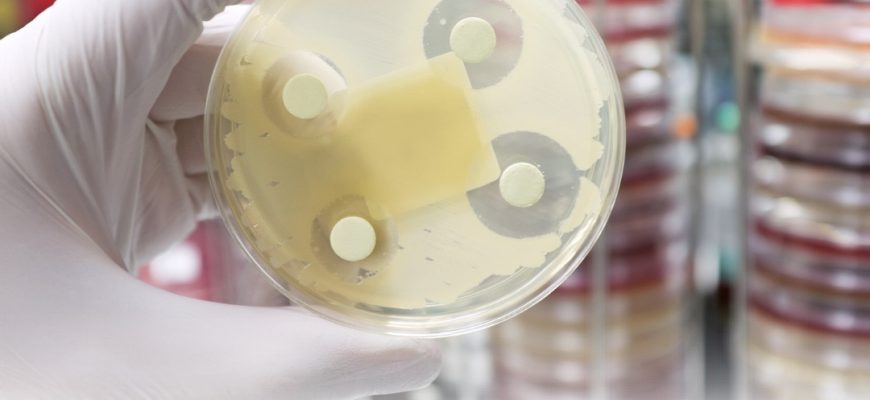

Устойчивость к противомикробным препаратам стала одной из самых острых проблем современности, несущей биологические и экономические угрозы для всех стран. Как же предотвратить антибиотикорезистентность?
Что такое антибиотики?
Антибиотики (антибактериальные препараты) — это продукты жизнедеятельности микроорганизмов (чаще всего грибов) и их синтетические производные, которые либо вызывают гибель бактерий, либо препятствуют их росту.
Антибиотики могут быть как в форме мази или крема для местного применения, так и в форме таблетки, раствора и суспензии, которые при попадании в организм распределяются по органам и тканям, действия на возбудителей инфекций.
Важно понимать, что строение вирусов и бактерий существенно различается, поэтому антибиотики бесполезны для борьбы с вирусами.
Почему к антибиотикам развивается устойчивость?
Приспосабливаться к неблагоприятным условиям внешней среды – это естественное свойство бактерий, к которым относится и выработка устойчивости или резистентности к антибиотикам.
Для того, чтобы сдержать развитие антибиотикорезистентности, важно соблюдать правила:
1. Применять антибиотики стоит только по назначению врача
Решение о применении противомикробных препаратов принимает врач, который исходит из жалоб пациента и результатов обследования. Самоназначение лекарств приводит лишь к усугублению заболевания, так как зачастую инфекции могут вызываться не только бактериями, но и вирусами.
2. Строго следовать рекомендациям врача относительно дозировки и длительности курса лечения
Часто люди прекращают применение антибиотиков при малейшем улучшении самочувствия или же наоборот превышают дозу и длительность курса, чтобы «уж наверняка» победить болезнь. Однако несоблюдения рекомендаций врача приведет лишь к затягиванию заболевания и развитию резистентности.
3. Не хранить антибиотики в домашней аптечке
Хранить оставшиеся препараты в аптеке не имеет смысла, так как вероятность того, что вам назначат тот же самый антибиотик крайне мала. При этом возрастает риск приема просроченного препарата, который не только теряет эффективность, но и является токсичным для организма.
4. Не давать советов по приему антибиотиков
Как неоднократно было сказано, только врач может подобрать оптимальный противомикробный препарат для конкретного случая. И даже если он помог вам, это вовсе не значит, что он поможет другому человеку. Многие заболевания имеют схожую симптоматику, но точный диагноз и необходимость применения того или иного препарата может установить только специалист.